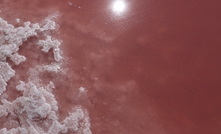
The project uses waste brine from seawater desalination to turn low-grade iron ore into high-grade feedstock

Munira Rajkotwalla
UNDERGROUND
Ericsson on 5G deployment at Cadia
Private 5G networks starting to prove their worth in mining
15 December 2025
COMMUNITY
Queensland coal royalty claims challenged
IEEFA says pressures such as labour shortages are the real cost to companies
10 November 2025
TECHNOLOGY
Turning waste brine into high-grade iron
Australia’s iron exports have relied on deposits from the Pilbara, but grades are steadily declining
31 October 2025
MANAGEMENT
Exclusive: Mark Cutifani on Vale exit, Rio's new chief, and the return of M&A
Cutifani sees strategy, skills and smart mergers as key to mining’s next phase
22 July 2025
UNDERGROUND
Epiroc struggles to cut customer emissions
Emissions have been cut in-house, but Epiroc machines are still producing high Scope 3s
21 March 2025
TECHNOLOGY
Why is mining's IoT uptake so slow?
A report by Viasat found that mining is lagging behind other industries
06 January 2025
MANAGEMENT
China's economic shift sends ripples through global mining
China's pursuit of clean energy is altering steel and iron demand
12 November 2024
TECHNOLOGY
Fleet Space lands Salares Norte work
Fleet Space's satellites will provide real-time 3D mineral mapping and AI-driven targeting
03 October 2024
PARTNER CONTENT
BHP Xplor looks to the future with tech-heavy 2026 cohort
More technology, more diversity
PARTNER CONTENT
Designing a Resilient Future: Innovation & Digital Transformation in Natural Resources
Buzzing Perth roundtable picks the brains of sector leaders to help shape the resources
PARTNER CONTENT
Reaching the Workforce: Mining Sites Turn to TV for Critical Communication
From flight schedules to emergency alerts, new screen-based platform Swift TV is helping mining companies better reach workers
PARTNER CONTENT
Weir Launches ESCO® Nexsys™ GET System for Rope Shovels
THE BEST GET BETTER: the new Nexsys system
Expert-led Insights reports built on robust data, rigorous analysis and expert commentary covering mining Exploration, Future Fleets, Automation and Digitalisation, and ESG.
Expert-led Insights reports built on robust data, rigorous analysis and expert commentary covering mining Exploration, Future Fleets, Automation and Digitalisation, and ESG.

Future Fleets Insights 2026
Mining IQ Insights delivers annual standalone reports that expand upon the most relevant discussion points in the mining sector.

ESG Index 2025: Benchmarking the Future of Sustainable Mining
The ESG Index provides an in-depth evaluation of the ESG performance of 60+ of the world’s largest mining companies. It assesses companies across 10 weighted indicators within 6 essential ESG pillars.

Automation and Digitalisation Insights 2025
Discover how mining companies and investors are adopting, deploying and evaluating new technologies.

Mining IQ Exploration Insights 2025
Gain exclusive insights into the world of exploration in a comprehensive review of the top trending technologies, intercepts, discoveries and more.
Content
SOLUTIONS